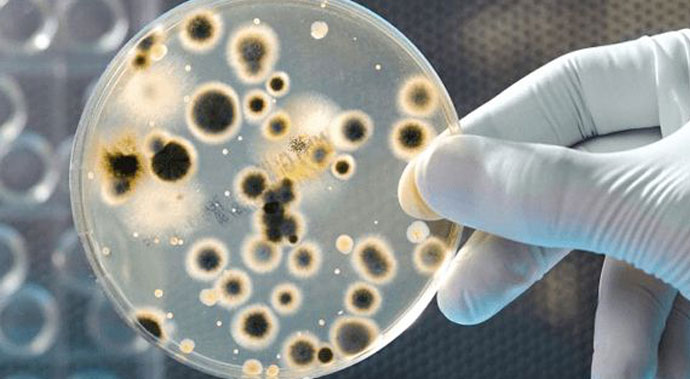

-
-
liqid00710 minute pentru a citi
Cel mai probabil, acum fiecare cititor va fi șocat: Am fost atacați de un inamic invizibil. Mai exact, acesta poate fi detectat doar după autopsie ... Este înfricoşător, nu-i așa? Dar realitatea este că EPIDEMIA PARAZITARĂ se răspândește în întreaga Europă la o rată turbulentă. Neașteptat, nu-i așa? Este secolul 21 și toată lumea a respectat mult timp igiena personală. Asta-i groaznic! Nici unul dintre cei infectați nu suspectează că are viermi ucigași.
G NDIȚI-VĂ doar la aceste cifre: peste 30 000 de persoane au murit de paraziți în întreaga Europă în ultima lună. Întrebați-vă de ce nu ați auzit nimic despre asta înainte? Răspunsul este simplu au ascuns. Epidemia este în creștere în fiecare zi, și guvernul nu mai este în măsură să ascundă informații. Sună ca un scenariu de film, doar că toți actorii mor cu adevărat.
Desigur, medicii nu au nici o idee cine a fost pacientul ne infectat și dacă nu a fost deloc. La un moment dat, a început în spitale starea de urgență. Oamenii au început să fie internați CU GRĂMADA. Medicii au fost de serviciu săptămâni întregi și nu s-au odihnit nici un minut. Plângerile au fost diferite, dar un astfel de simptom comun, cum ar fi vărsăturile sau temperaturile, nu au existat. La fiecare om paraziți s-au manifestat individual.
Problema este că specii de viermi sunt trilioane și pot afecta orice organ uman. Ce, ați crezut că e un vierme și atât, care e de vina? Nu a fost să fie. Când au început studiile în masă, medicii au fost îngroziți. În primul rând, ei au descoperit adevărata cauză a oamenilor bolnavi și, în al doilea rând, un număr foarte mare de microorganisme necunoscute care evoluează.
S-a dovedit că, cu o cură întârziată sau incorectă, în cel mai bun caz, o persoană poate rămâne invalidă. Și NICI UN produs cunoscut nu poate ucide acești paraziți...
De unde provin paraziții? Teritoriu infectat
Nu știu exact de unde au venit. Ca întotdeauna, există o mulțime de opțiuni, de la cele logice la cele fabuloase. Colegul meu spune că toți paraziți au provenit de la refugiați, iar soția lui este sigură că e vorba de extratereștri. Într-un singur lucru sunt sigur 100%: dacă merge mai departe, consecințele vor fi mai rele decât ciuma bubonică din Evul Mediu…
Deocamdată este versiunea oficială, că din cauza calamităților naturale, încălzirii globale și deteriorarea situației ecologice, paraziții din Asia au suferit mutaţii și s-au adaptat la noile condiţiile meteorologice. În prezent, principalul focar de distribuție este partea centrală și de sud a Europei.
Dinamica arată o mișcare activă spre est, vest și nord, unde sunt deja înregistrate decese.
Cum să afli dacă ești infectat?
G NDEȘTE-TE! Absolut toată lumea se poate infecta cu paraziți, indiferent de vârstă și frecvența spălării mâinilor. Transportul public, numărarea banilor sau alimentare incorectă pot fi cauza. Nu există nici o șansă, înțelegi?
Paraziții trăiesc în corpul nostru. Distrug țesuturile interne, se hrănesc cu sânge, migrează prin toate organele, lăsând urme toxice ale activității lor vitale.
La început după infectare, paraziții provoacă: balonare, oboseală rapidă, slăbiciune, cefalee, insomnie. Apoi migrează și se înmulțesc, ceea ce cauzează: probleme gastrointestinale, vasculare, dureri articulare și musculare, reacții alergice, anemie, probleme de greutate, scrâșnirea dinților în somn (bruxism), inflamația căilor respiratorii, tulburări imune.
După 2-6 luni, practic nu va rămâne organul, muschii și țesutul osos. Acest lucru duce la complicații grave și chiar rezultând în deces.
Cu toate acestea, moartea este constatată din alte motive. Când am aflat despre asta, m-am îngrozit. CUM AȘA? De ce ar face asta? Este un nou tip de armă biologică, care va șterge în curând omenirea de pe fața pământului?
Există o cale de ieșire din această situație? - DA!
Să administrezi o pastilă obișnuită pentru viermi? Nu va ajuta. Toate remediile cunoscute anterior sunt inutile. Avem nevoie de ceva nou. Și cel mai ciudat lucru este că produsul există deja – Sanixol. Produsul antiparazitar de origine vegetală este dezvoltat la Institutul de Parazitologie și Medicină Tropicală. Acest produs într-un experiment clinic a demonstrat o eficacitate imensă atât împotriva organismelor patogene recent descoperite, cât și împotriva tuturor paraziților deja cunoscuți.
Sanixol are un efect ușor, se absoarbe încet în tractul gastro-intestinal, se leagă de proteinele plasmatice și se distribuie in tot corpul.
Spre deosebire de alte produse antiparazitare, Sanixol:
- este elaborat exclusiv din materii prime naturale fără adăugarea componentelor chimice;
- ajuta la îndepărtarea viermilor și larvelor adulte și a deșeurilor toxice ale acestora;
- ajuta la refacerea celulelor deteriorate ale organelor interne;
- acționează de la prima utilizare și îmbunătățește organele cu fiecare administrare.
Ce trebuie făcut pentru a evita infectarea?
Puteți cumpăra un costum de protecție, dar nu vă va ajuta. Și atunci când se administrează Sanixol organismul produce o cochilie protectoare la nivel celular, deja rezistentă la infecție.
În sfârșit, vreau să spun că este real și legal să cumpărați Sanixol. Este suficient să lăsați o cerere pe site-ul oficial. Personal, am cumpărat deja produsul și pe voi vă sfătuiesc.
Protejează-te pe tine și familia ta, deoarece TOATĂ LUMEA poate fi infectată. Mâncarea, apa, transportul public, îmbrăcămintea, biroul și animalele de companie te-ar putea infecta.
COMANDĂ Sanixol

26.08.2021
27.08.2021
27.08.2021
28.08.2021
29.08.2021
30.08.2021
31.08.2021
1.09.2021
1.09.2021
3.09.2021
5.09.2021
6.09.2021
7.09.2021
9.09.2021
10.09.2021
12.09.2021
13.09.2021